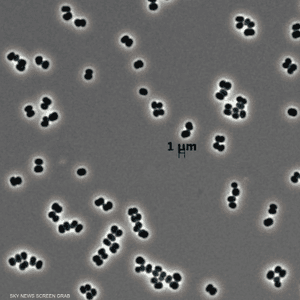
البكتيريا تتظاهر بالموت

ترك الصحون منقوعة ليلا بالمطبخ.. أخطر مما تتصور
16:52 - 29 ديسمبر 2025
حذر خبراء من أن ترك الأواني المتسخة منقوعة في الماء طوال الليل يمكن أن يحول حوض المطبخ إلى بيئة مثالية لتكاثر البكتيريا الخطيرة المرتبطة بالتسمم الغذائي وأمراض أخرى.
يعتاد كثير من الأشخاص ترك أطباقهم المتسخة بعد تناول الطعام منقوعة أو مكدسة في حوض المطبخ حتى الصباح، من دون إدراك أن هذا السلوك البسيط قد يشكل خطرا صحيا.
وأكد علماء الأحياء الدقيقة أن الظروف الدافئة والرطبة التي يوفرها نقع الصحون وأدوات المائدة في أحواض المطبخ تساهم في تكاثر الميكروبات الضارة.
وقال عالم الأحياء الدقيقة جايسون تيتور: "بصفتي عالم أحياء دقيقة، أرى أن حوض المطبخ ملاذًا مثاليًا للمكروبات وانتقالها".
وأوضح أن الدراسات أظهرت أن حوض المطبخ هو المكان الذي تتجمع فيه أنواع مختلفة من البكتيريا غير المرغوب فيها، بما في ذلك بكتيريا القولون البرازية ومسببات الأمراض المنقولة بالغذاء وحتى بكتيريا الجلد.
كما أظهرت أبحاث أجرتها جامعة كارديف متروبوليتان، شملت مسح الأسطح في مطابخ 46 منزلا في أنحاء بريطانيا، أن الأحواض تحتوي على بكتيريا أكثر من أي منطقة أخرى في المطبخ، وفقا لصحيفة "ديلي ميل" البريطانية.
وأشار خبراء إلى أن ذلك يعود جزئيا إلى استخدام الأحواض في تحضير الطعام النيئ، إذ اعترف العديد من الأشخاص بغسلهم الدواجن واللحوم قبل طهيها، ما يساعد على نشر البكتيريا في المطبخ.
وتعد بكتيريا الإشريكية القولونية من أكثر الميكروبات رصدا في أحواض المطابخ، وترتبط هذه البكتيريا، القاتلة في بعض الحالات، بالحمى والقيء والإسهال، إلى جانب زيادة احتمال الإصابة بسرطان القولون، خصوصًا لدى الأشخاص دون الخمسين.
وأوضح براين لابوس، خبير الصحة العامة في جامعة نيفادا، أن ترك الأطباق المتسخة مكدسة بجانب الحوض أمر خطير.
وأضاف أن "تكاثر البكتيريا يكون أوضح في البيئات الدافئة والرطبة، وهو ما ينطبق تماما على حوض المطبخ عند نقع الأواني. صحيح أن البيئات الجافة قد تمنع نمو البكتيريا، لكن هذا لا يعني أنها لا تستطيع البقاء أو النمو لاحقا، كما أن ترك بقايا الطعام مكشوفة قد يجذب الحشرات التي تنقل البكتيريا إلى بقايا الطعام".
ولتقليل خطر الإصابة بالتسممات الغذائية، ينصح الخبراء باستخدام غسالة الصحون، لأنها تغسل الأطباق تحت درجة حرارة مرتفعة، ما يساهم في قتل الميكروبات الضارة.
كما توصي هيئة المعايير الغذائية البريطانية (FSA) بتجنب غسل اللحوم النيئة لما قد يخلفه ذلك من بكتيريا على الأسطح والأدوات والأطعمة المحيطة.
وجاءت هذه التحذيرات في ظل حالات التسمم الغذائي في بريطانيا خلال العام الماضي، إذ أسفرت عن مقتل شخصين ودخول أكثر من 100 شخص إلى المستشفى، إلى جانب إصابة 300 شخص آخرين بالمرض.